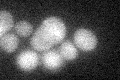
YEL012W
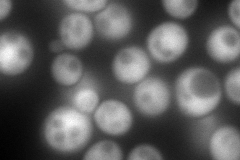
YEL012W
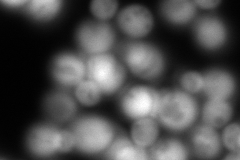
YEL012W
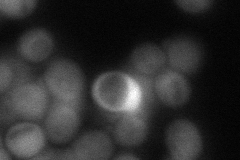
YEL012W
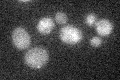
YEL012W

View description
Ubiquitin-conjugating enzyme that negatively regulates gluconeogenesis by mediating the glucose-induced ubiquitination of fructose-1,6-bisphosphatase (FBPase); cytoplasmic enzyme that catalyzes the ubiquitination of histones in vitro
Localization:
Intensity:
Fold change:
Significance:
-
C’ GFP library in SD
below threshold17.37 -
N' NOP1pr-GFP in SD
cytosol,nucleus307.569 -
N' TEF2pr-mCherry in SD
cytosol557.696 -
N' NATIVEpr-GFP in SD
nucleus61.2671 -
N' TEF2pr-VC and Cyto-VN in SD

#N/A0 -
C’ GFP library in SD+DTT

cytosol15.90.91No -
C’ GFP library in SD+H2O2

cytosol18.71.07No -
C’ GFP library in Starvation Media
cytosol20.421.17No -
C’ GFP library on the background of Pup2-DaMP

below threshold -
C’ GFP library on the background of CCT mutant

below threshold16.76640.964742No
